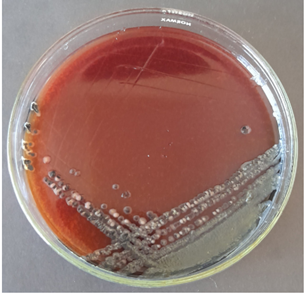
Gambar 1. Contoh koloni bakteri pada Koloni bakteri pada Salmonella Shigella Agar (Zain dkk., 2021)

Pendahuluan
Pertumbuhan mikroorganisme pada produk makanan dan minuman telah menjadi perhatian serta perdebatan selama bertahun-tahun. Dari sisi kesehatan, keberadaan mikroba patogen dalam produk tersebut membuatnya berisiko dan berbahaya bagi konsumen. Mikroba patogen seperti Salmonella, Listeria monocytogenes, atau Escherichia coli dapat menyebabkan penyakit serius, mulai dari diare ringan hingga gastroenteritis akut, tergantung pada jumlah mikroba dan sensitivitas individu terhadap toksin yang dihasilkan. Selain itu, mikroba juga dapat mengubah sifat fisik, kimia, dan biologis bahan dalam produk, bahkan menghasilkan zat beracun. Oleh karena itu, deteksi cepat mikroba dalam makanan dan minuman menjadi langkah penting untuk menjaga keamanan pangan, kualitas produk, dan kesehatan konsumen.
Gambar 1. Contoh koloni bakteri pada Koloni bakteri pada Salmonella Shigella Agar (Zain dkk., 2021)
Dalam mendeteksi mikroorganisme patogen, terdapat metode klasik seperti kultur mikroba dan uji biokimia yang seringkali memerlukan waktu inkubasi yang panjang sekitar 24 – 72 jam sehingga kurang ideal untuk kebutuhan pemeriksaan cepat di lingkungan industri. Oleh karenanya, dikembangkan suatu metode metode untuk memenuhi kebutuhan akan hasil yang lebih cepat tanpa harus menunggu pertumbuhan mikroba secara tradisional serta tetap menjaga akurasi pemeriksaan yang dikenal dengan Rapid Testing Microbiology (Nemati dkk., 2016).
Secara lebih lanjut, Nemati dkk., menjelaskan bahwa rapid testing microbiology merupakan kumpulan metode diagnostik yang dirancang untuk mempercepat identifikasi mikroorganisme, karakterisasi produk mikrobiologi, atau penentuan kepekaan antimikroba, tanpa harus melalui proses laboratorium konvensional yang memakan waktu panjang. Metode ini penting dalam pemeriksaan kualitas produk farmasi dan makanan, hingga pemeriksaan lingkungan. Metode rapid testing seringkali menggabungkan teknologi biologi molekuler, imunologi, atau sensor mikrobiologi canggih untuk memberikan data deteksi secara cepat dan efektif.
Rapid Microbial Testing dalam Industri Makanan dan Minuman
Sebagai metode yang bertujuan untuk mendeteksi keberadaan mikroba atau menghitung jumlah total mikroba dalam sampel pangan dengan cepat, metode ini memiliki beberapa tujuan sebagai berikut.
Dalam industri makanan dan minuman, rapid microbial testing umumnya menggunakan dua pendekatan utama, yaitu penghitungan mikroba secara cepat (rapid enumeration) dan deteksi spesifik mikroorganisme patogen (rapid detection). Pendekatan ini dikembangkan untuk menjawab kebutuhan industri akan metode pengujian yang tidak hanya akurat, tetapi juga mampu memberikan hasil dalam waktu yang lebih singkat dibandingkan metode kultur konvensional yang memerlukan inkubasi panjang. Penggunaan metode cepat memungkinkan produsen melakukan pengendalian mutu secara real-time, sehingga potensi kontaminasi dapat dideteksi lebih awal sebelum produk didistribusikan ke konsumen.
Rapid Enumeration
Metode ini menggunakan count plates yang bertujuan untuk menghitung jumlah mikroorganisme tertentu seperti total bakteri aerob, coliform, kapang, dan khamir dalam sampel makanan atau minuman. Metode ini mengintegrasikan media selektif dan indikator pertumbuhan dalam satu sistem yang praktis, sehingga proses persiapan media, inokulasi, dan pembacaan hasil menjadi lebih sederhana dan efisien. Rapid count plates banyak digunakan dalam pengujian rutin industri pangan karena mampu memberikan gambaran cepat mengenai tingkat kontaminasi mikroba dan kesesuaian produk terhadap standar keamanan pangan (Liborio dkk., 2024).
Rapid Molecular Detection Kits
Pendekatan kedua adalah rapid detection berbasis metode molekuler, yang difokuskan pada identifikasi mikroorganisme patogen spesifik seperti Salmonella, Listeria monocytogenes, dan Staphylococcus aureus. Metode ini bekerja dengan mendeteksi materi genetik mikroba secara langsung dari sampel, sehingga tidak bergantung pada pertumbuhan koloni yang memerlukan waktu lama. Keunggulan utama dari pendekatan ini adalah tingkat sensitivitas dan spesifisitas yang tinggi, serta kemampuan untuk mendeteksi patogen dalam jumlah kecil. Oleh karena itu, rapid molecular detection sangat bermanfaat dalam sistem jaminan mutu dan keamanan pangan untuk mencegah risiko kesehatan konsumen dan potensi penarikan produk dari pasaran.
| Pembeda | Count Plates | Rapid Molecular Detection Kits |
| Contoh | Aerobic Count Plate, Coliform Count Plate, Salmonella Count Plate, Mold & Yeast Count Plate | Teknologi molekuler, seperti PCR cepat atau LAMP. |
| Fungsi | Menghitung jumlah koloni mikroba target dalam sampel secara cepat. | identifikasi spesifik patogen seperti Salmonella, Listeria monocytogenes, Staphylococcus aureus, dan Pseudomonas aeruginosa. |
| Keunggulan | Mengurangi kebutuhan media manual dan mempercepat proses hitung dibanding metode plating konvensional. | Hasil lebih cepat dan spesifik, cocok untuk skrining kualitas pangan dan minuman sebelum distribusi. |
Manfaat Rapid Testing Microbiology
Rapid microbial testing memberikan berbagai manfaat penting dalam industri pangan sebagai berikut.
Produk HKMBio
Untuk memenuhi kebutuhan industri pangan akan pemeriksaan mikroba cepat, HKMBio melalui Huankai Group menghadirkan berbagai produk rapid microbial testing yang dirancang khusus untuk sampel makanan dan minuman. HKMBio menawarkan rapid microbial testing kits dan plates yang khusus untuk aplikasi industri pangan dan laboratorium mikrobiologi. Tidak hanya itu, HKMBio juga menyediakan rapid detection kits berbasis molekuler untuk mendeteksi patogen spesifik seperti Salmonella, Listeria monocytogenes, Staphylococcus aureus, dan Pseudomonas aeruginosa dalam sampel makanan atau air. Kit ini menggunakan teknologi amplifikasi asam nukleat, sehingga hasil dapat diperoleh dalam waktu singkat, mendukung pengendalian mutu dan keamanan mikrobiologi di industri maupun laboratorium.
| Nomor Catalog | Deskripsi Produk | Size |
| PCR Kits | ||
| 075150 | Urea biochemical identification kit
|
20 vials/box |
| FZ001BF2 | Rapid Detection Kit for Pseudomonas Aeruginosa![]() |
Kit |
| FZ009BF2 | Rapid Detection Kit for Escherichia Coli O157: H7![]() |
Kit |
| Handy Plate | ||
| HP001 | Aerobic Count Plate![]() |
20 plates |
| HP002 | Coliform Count Plate![]() |
20 plates |
| HP003 | Yeast and Mold Count Plate![]() |
20 plates |
| HP004 | Coliform and E. coli Count Plate![]() |
20 plates |
| HP005 | Salmonella Count Plate![]() |
20 plates |
| HP006 | Cronobacter Sakazakii Detection Plate![]() |
20 plates |
| HP007 | Staphylococcus Aureus Count Plate![]() |
20 plates |
| HP011 | Rapid Aerobic Count Plate![]() |
20 plates |
| HP012 | Rapid Mold and Yeast Count Plate![]() |
20 plates |
Untuk pertanyaan produk dan stock lebih lanjut Bapak/Ibu dapat menghubungi kontak yang tertera pada laman website Indogen berikut. Terima kasih.
Referensi :
Hidanah, Sri & Damayanti, Ratna & Warsito, Sunaryo. (2021). Detection of Salmonella sp. on Bulk Meatballs and Packaged Meatballs at Sepanjang Market, Sidoarjo. Journal of Applied Veterinary Science And Technology. 2. 31.
Jiang, L., Zhang, B., Liu, S. et al. The MBS microbial rapid detection system for rapid detection of major pathogenic bacteria in feed: comparison with plate counting method. BMC Microbiol 22, 242 (2022). https://doi.org/10.1186/s12866-022-02655-2
Liborio, M. P., Harris, P. N. A., Ravi, C., & Irwin, A. D. (2024). Getting Up to Speed: Rapid Pathogen and Antimicrobial Resistance Diagnostics in Sepsis. Microorganisms, 12(9), 1824. https://doi.org/10.3390/microorganisms12091824
Nemati, M., Hamidi, A., Maleki Dizaj, S., Javaherzadeh, V., & Lotfipour, F. (2016). An Overview on Novel Microbial Determination Methods in Pharmaceutical and Food Quality Control. Advanced pharmaceutical bulletin, 6(3), 301–308. https://doi.org/10.15171/apb.2016.042
Artikel Terkait